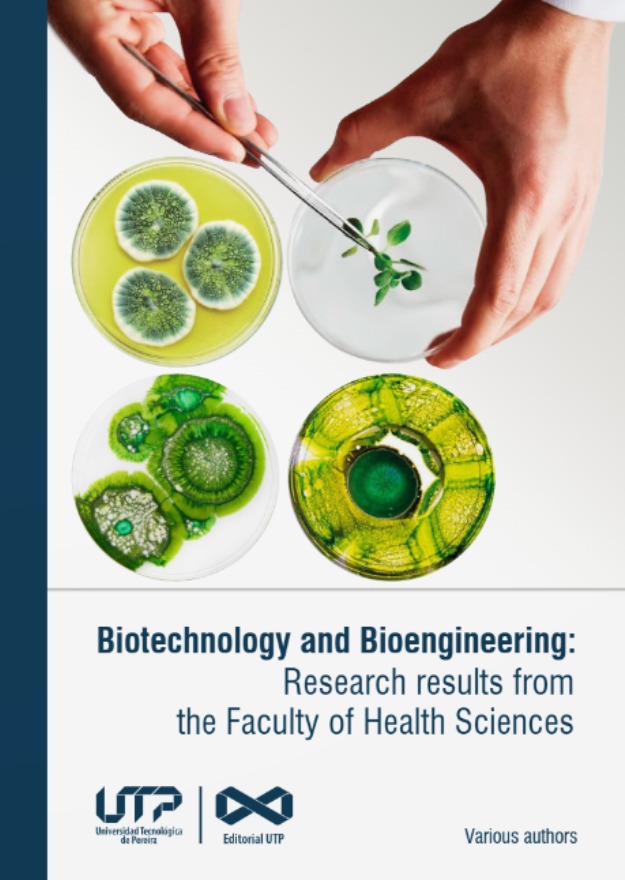

La Universidad Tecnológica de Pereira continúa fortaleciendo su presencia en escenarios de alto impacto académico y cultural, y en esta oportunidad, la Facultad de Ciencias de la Salud será protagonista en la Feria Internacional del Libro de Bogotá 2026, considerada la más importante del país y una de las más relevantes en Latinoamérica.

Con una destacada producción editorial, la Facultad presentará cinco novedades que reflejan el trabajo investigativo, académico y científico de docentes, estudiantes y grupos de investigación, consolidando su aporte al avance del conocimiento en el campo de la salud.
El decano de la Facultad de Ciencias de la Salud, Giovanni García Castro, también autor de una de la novedades que se presentarán en la FILBo 2026, destacó la importancia de esta participación señalando que “nuestra Facultad es una Facultad activa desde el punto de vista editorial, sobre todo desde lo que tiene que ver con investigación en áreas de la salud”.
Entre las obras que estarán presentes en la feria se encuentra:
- “Enfermedad Pulmonar Post-Tuberculosis (PTLD): Perspectivas clínicas, funcionales y sociales”, un libro que aborda esta condición desde una mirada integral, incluyendo dimensiones clínicas, biológicas y sociales, así como su impacto en la calidad de vida de los pacientes.
- “Atlas de Parasitología Médica”, una obra práctica que facilita la identificación de parásitos y el estudio de las patologías asociadas, convirtiéndose en una herramienta clave para profesionales y estudiantes del área de la salud.
- “Fundamentos del voleibol”, una obra que aborda este deporte desde su dimensión histórica, social y técnica, integrando el conocimiento del deporte con las ciencias de la salud.
En el ámbito de la investigación internacional, la Facultad presentará dos libros en inglés:
- “Biotechnology and Bioengineering: Research results from the Faculty of Health Sciences” y “Advances in health sciences: clinical education and public health research”, que recopilan resultados de investigación en áreas biomédicas, clínicas y de salud pública, fortaleciendo la visibilidad global de la producción académica de la Universidad.
Asimismo, el decano resaltó que estas publicaciones son el resultado del trabajo articulado entre diferentes áreas del conocimiento, “son obras muy interesantes, producto del trabajo de nuestros docentes, estudiantes y grupos de investigación que vienen a aportar a las novedades editoriales de la Universidad en la Feria del Libro”. Además, enfatizó el alcance de estas obras, indicando que “aportan a esa visibilidad y ese avance de la ciencia desde nuestra institución”, consolidando a la UTP como un referente en producción académica e investigativa.
La participación en la FILBo 2026 representa una oportunidad estratégica para proyectar el conocimiento generado en la Universidad hacia escenarios nacionales e internacionales, promoviendo el acceso abierto, el diálogo académico y la apropiación social del conocimiento. La Facultad de Ciencias de la Salud consolida así su compromiso con la investigación, la formación de calidad y la generación de conocimiento que impacta positivamente la sociedad.











